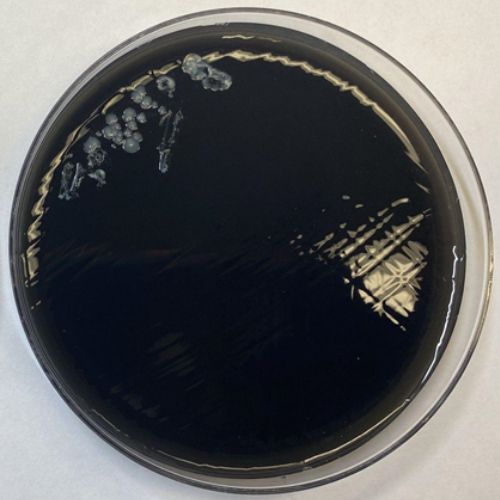

Posts
Media
Videos
Starter Packs
pascv.bsky.social
@pascv.bsky.social
· Feb 12
pascv.bsky.social
@pascv.bsky.social
· Nov 25